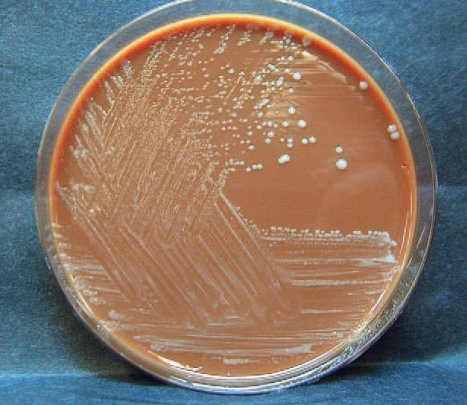

🔹️ X = hemin
🔹️ V = nicotinamide adenine dinucleotide ( NAD )
🔸️ العينات التي نحتاجها للتشخيص هي :
1- Nasopharyngeal swap
2- Pus
3- Blood
4- CSF
بالاعتماد على مكان الإصابة
🔹️ V = nicotinamide adenine dinucleotide ( NAD )
🔸️ العينات التي نحتاجها للتشخيص هي :
1- Nasopharyngeal swap
2- Pus
3- Blood
4- CSF
بالاعتماد على مكان الإصابة
🔸️العلاج ( Treatment ) 💊 :
هناك عدة مضادات حيوية ( Antibiotics ) من الممكن أن تستخدم لعلاج الهيموفلس منها:
- Ampicilin
- Cefotaxime
- Ceftriaxone
- Rifampin
يجب أن يكون العلاج بأسرع وقت ممكن لعدم حدوث مضاعفات خصوصاً المضاعفات العصبية ( Neurological disorders ) لدى الأطفال
هناك عدة مضادات حيوية ( Antibiotics ) من الممكن أن تستخدم لعلاج الهيموفلس منها:
- Ampicilin
- Cefotaxime
- Ceftriaxone
- Rifampin
يجب أن يكون العلاج بأسرع وقت ممكن لعدم حدوث مضاعفات خصوصاً المضاعفات العصبية ( Neurological disorders ) لدى الأطفال
جاري تحميل الاقتراحات...